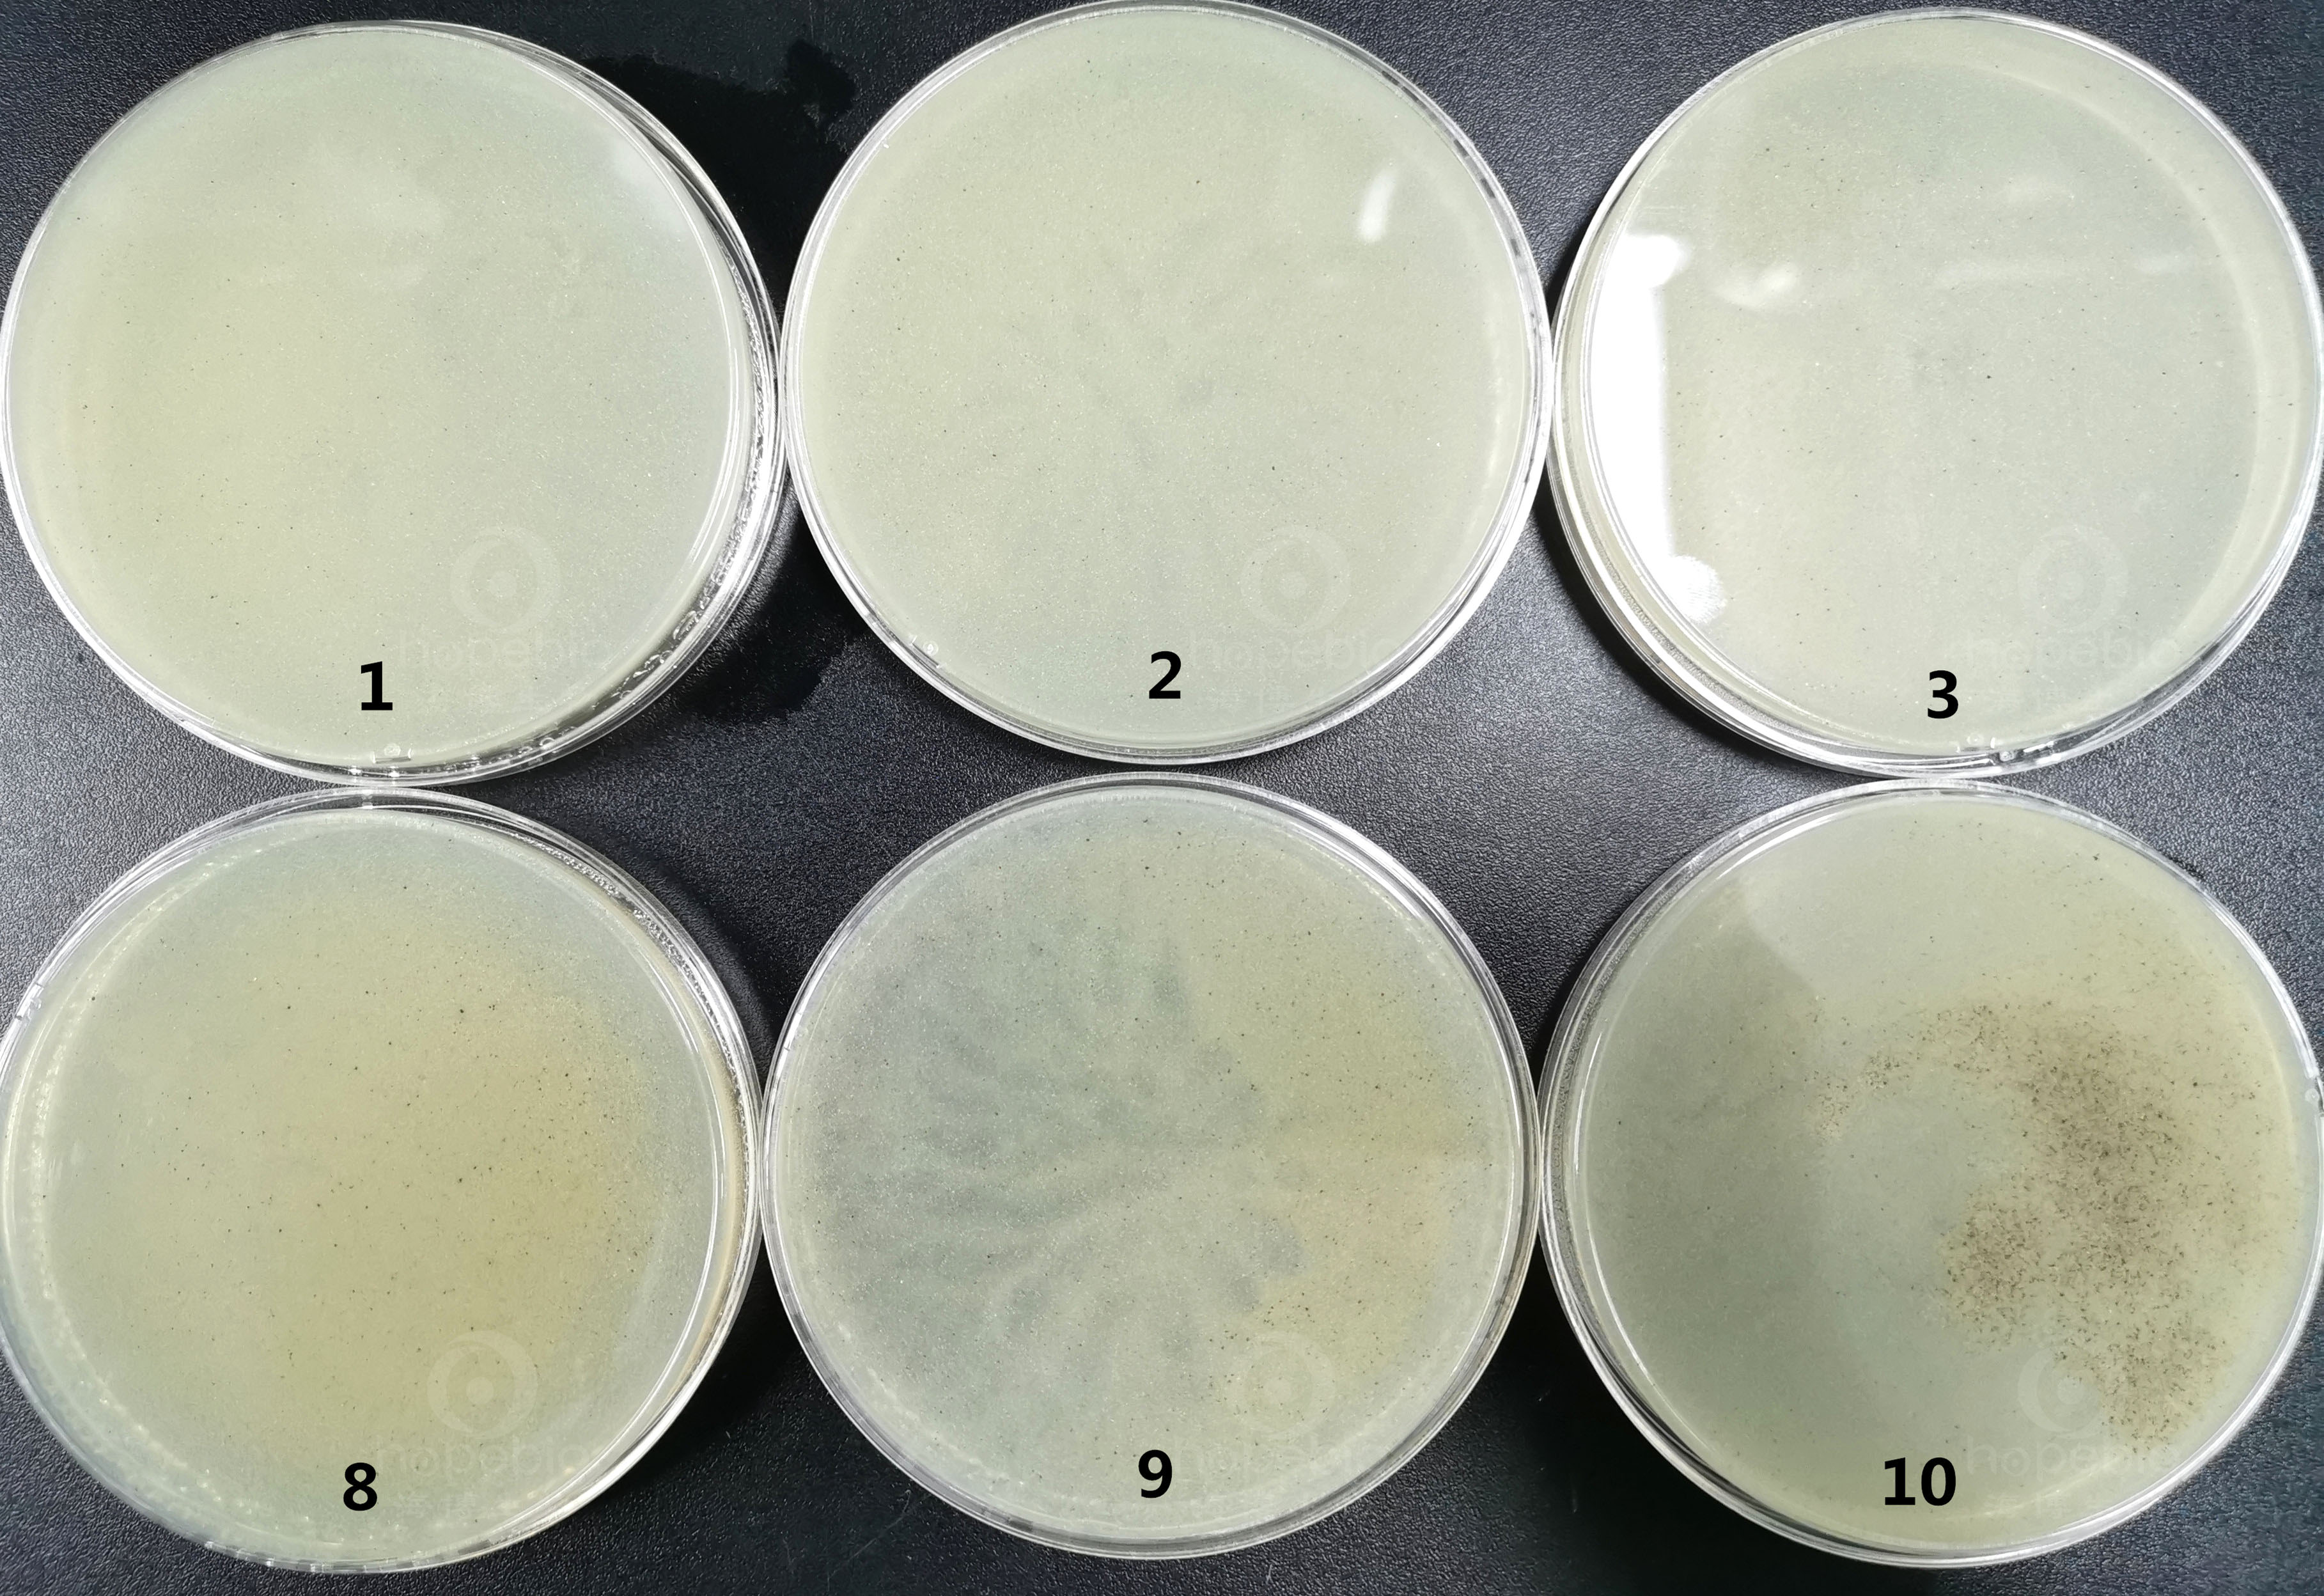
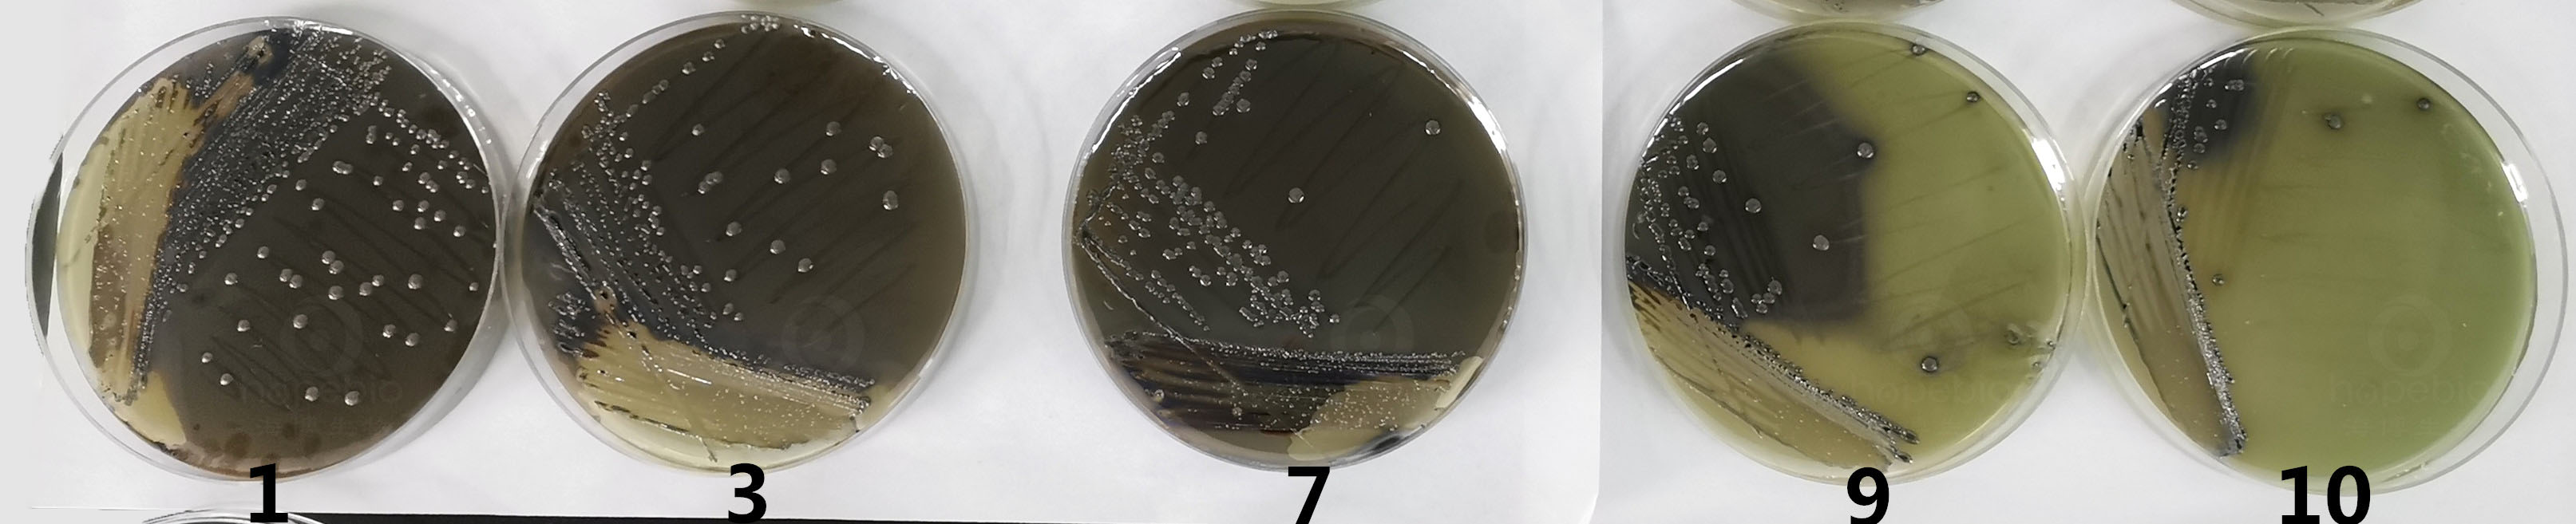
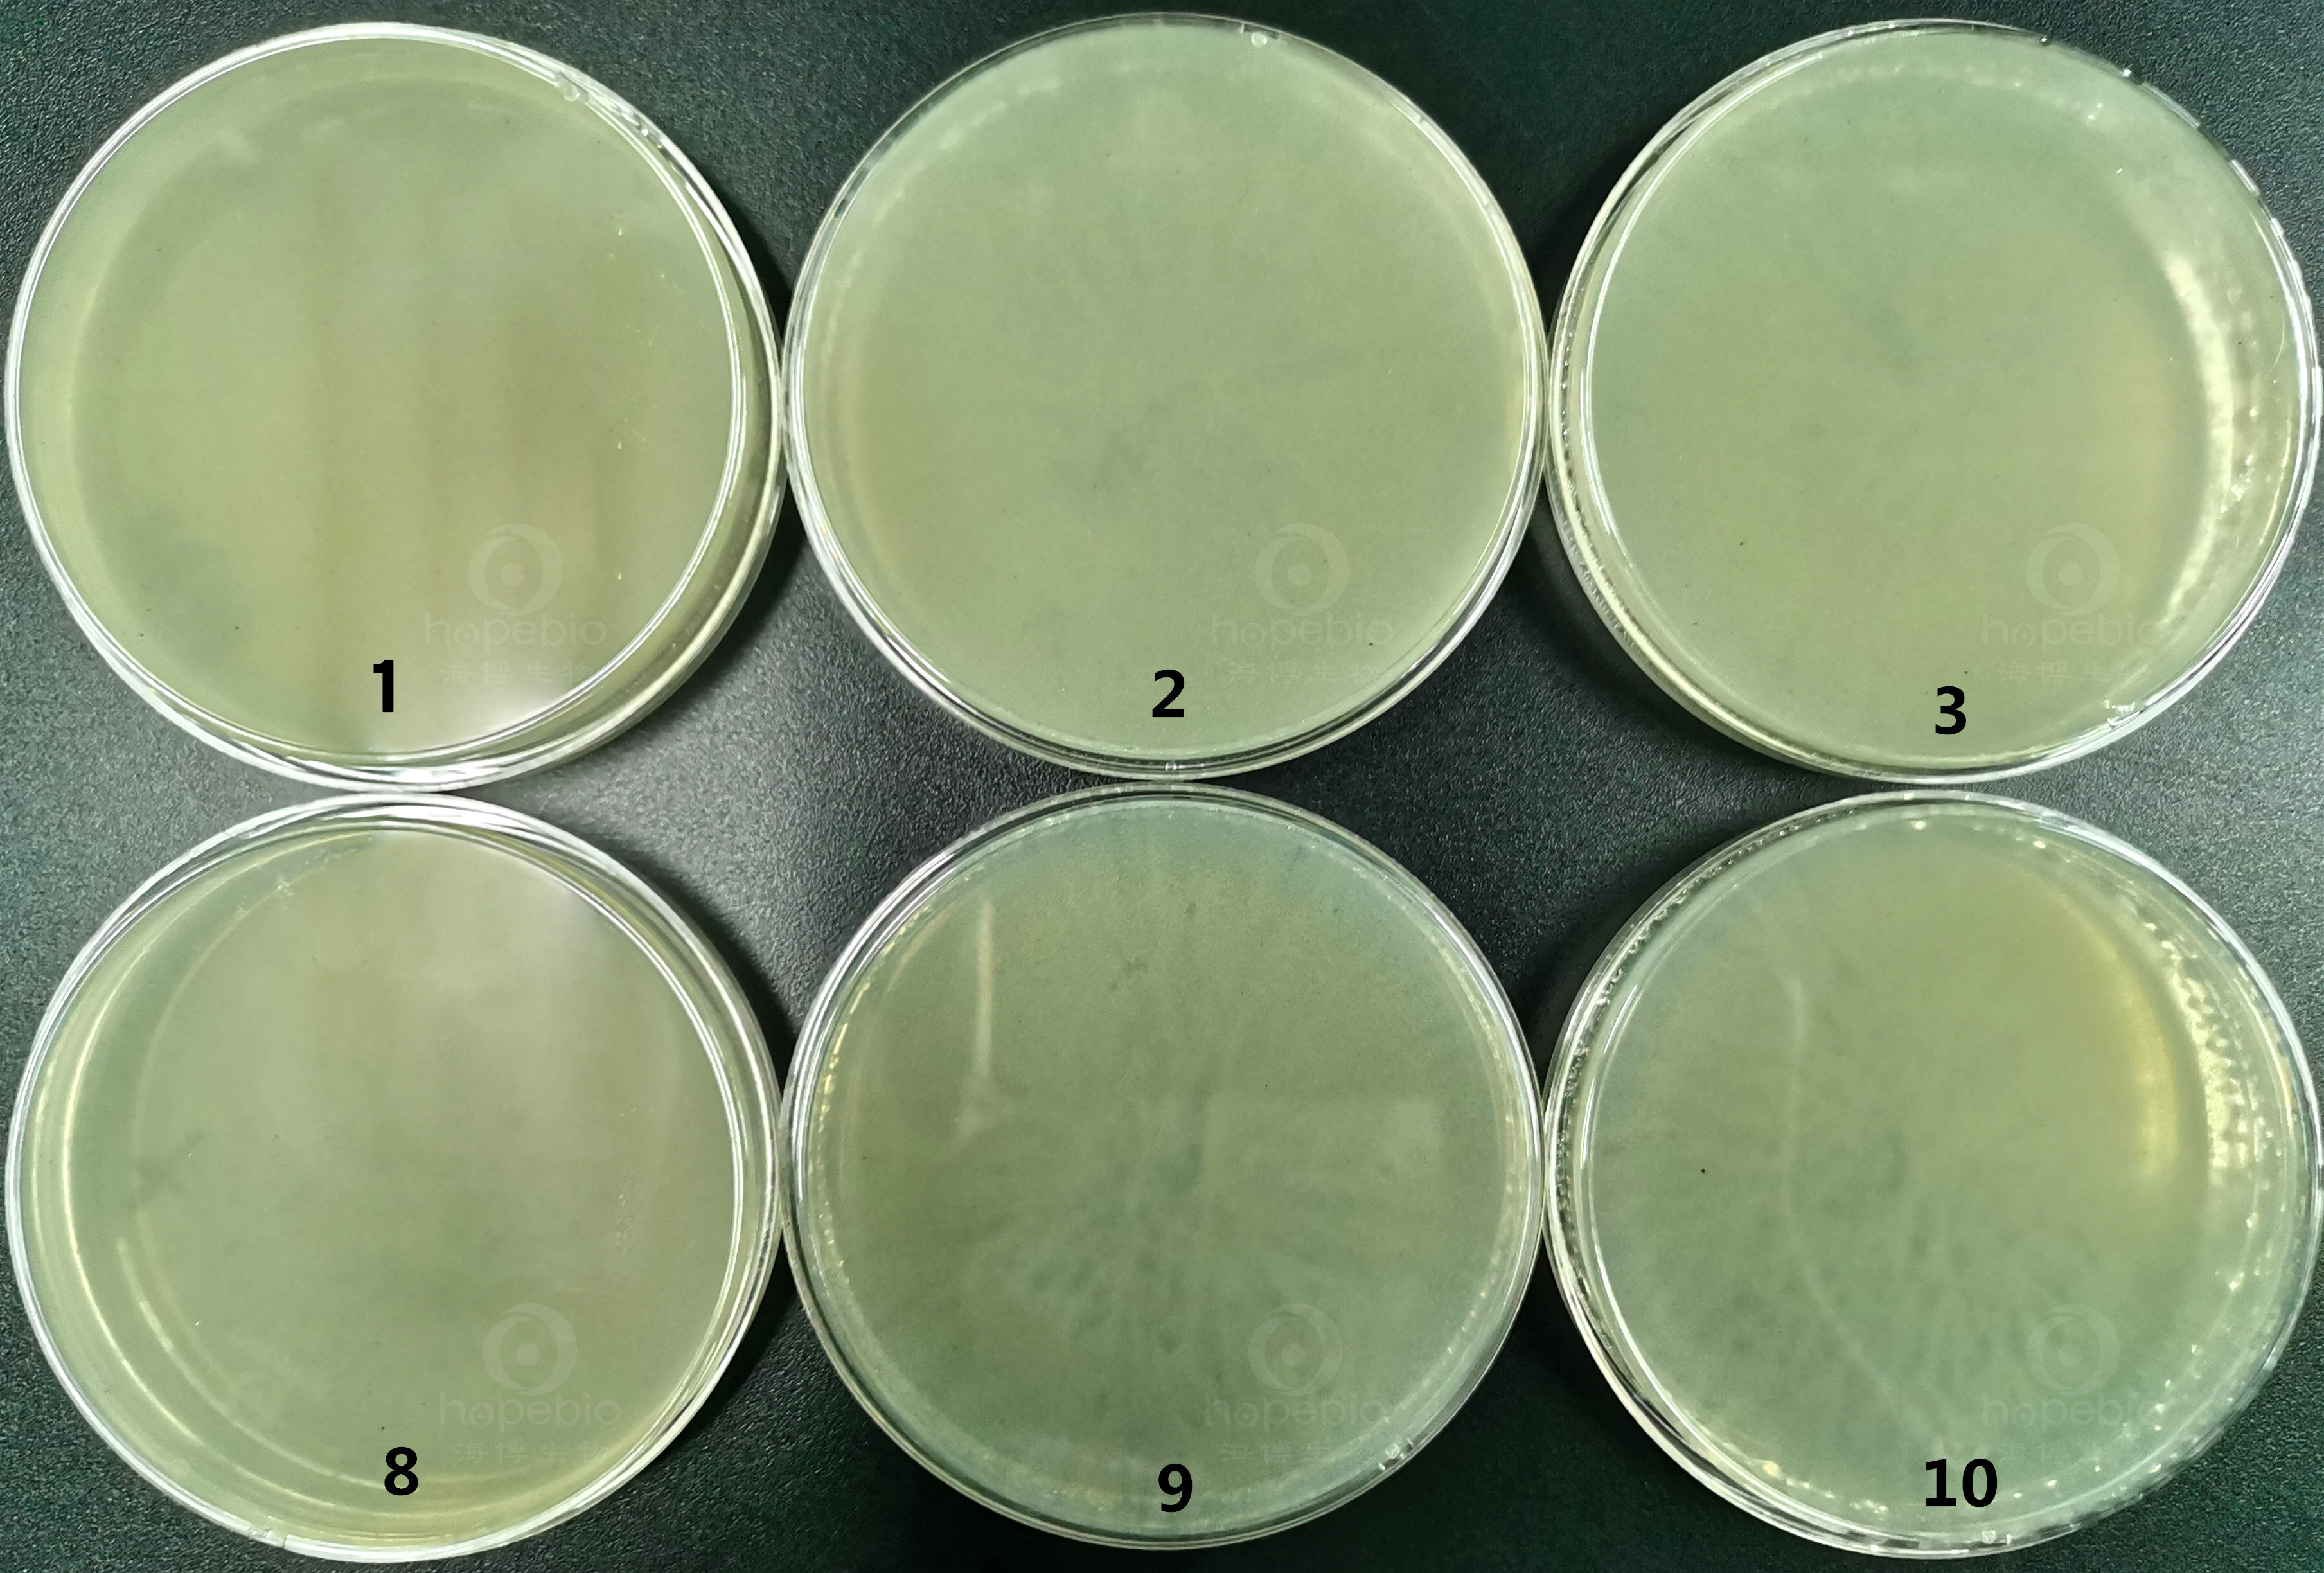
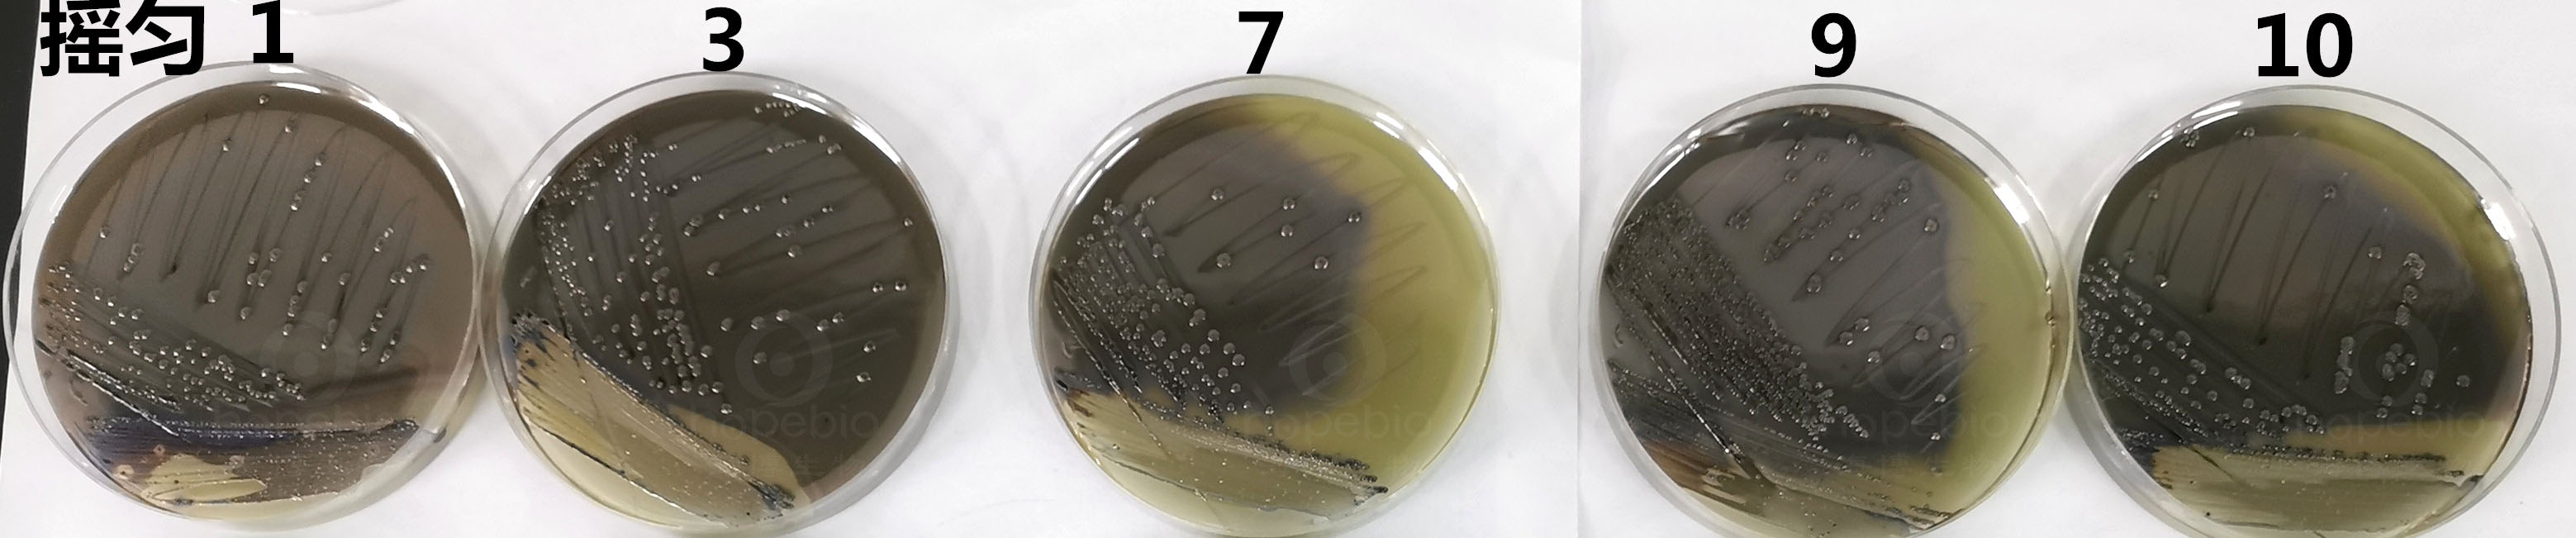

海博微信公众号
海博微信公众号
 海博天猫旗舰店
海博天猫旗舰店


 海博微信公众号
海博微信公众号
 海博天猫旗舰店
海博天猫旗舰店




一、背景简介
沙门氏菌很容易引起中毒,人一旦摄入含有大量沙门氏菌的动物性产品,就会引起细菌性感染,进而在毒素作用下发生食物中毒。肉、蛋以及食品从加工到出售的过程中都十分容易发生沙门氏菌的传播污染, 禽沙门氏菌可以引起禽白痢、伤寒、副伤寒等疾病, 并污染食物, 造成人类食物中毒。因此对沙门氏菌检测事关重大。
亚硫酸铋琼脂培养基,简称BS琼脂,主要用于沙门氏菌的检测。在《GB4789.4-2016 食品安全国家标准 食品微生物学检验 沙门氏菌检验》中,这是一款必须用到的培养基。
沙门氏菌检验程序见图一。

图一
关于BS琼脂,具体可参考文章:亚硫酸铋琼脂(BS)原理和使用方法 。
二、面临的问题
在实际配制使用过程中,经常会有实验人员反馈,这种培养基制成的平板底部有黑渣,并且盛放培养基的搪瓷缸底部也会有很多黑渣沉淀,有的人甚至怀疑是培养基原料没有溶解或者培养基本身有杂质所致。本文主要就这一问题做一探讨。
三、原因探究
首先,来看该培养基的配方,成分(g/L)。
|
蛋白胨 |
10.0 |
|
牛肉浸粉 |
5.0 |
|
葡萄糖 |
5.0 |
|
硫酸亚铁 |
0.3 |
|
磷酸氢二钠 |
4.0 |
|
煌绿 |
0.025 |
|
柠檬酸铋铵 |
2.0 |
|
亚硫酸钠 |
6.0 |
|
琼脂 |
20.0 |
|
pH值7.5±0.2 |
25℃ |
柠檬酸铋铵在水热过程中能分解出NH4+,柠檬酸根在水热过程中分解产生CO32-,部分Bi3+被还原成Bi单质;金属Bi呈粉红色;硫酸亚铁中的Fe2+也可能形成Fe3+等形式。这些离子之间相互反应,不可避免地产生了一些带颜色的沉淀物。
四、问题解决
下面再来看一下,GB4789.4-2016中对该培养基配制方法的叙述:
将前三种成分加入300mL蒸馏水(制作基础液),硫酸亚铁和磷酸氢二钠分别加入20mL和30mL蒸馏水中,柠檬酸铋铵和亚硫酸钠分别加入另一20mL和30mL蒸馏水中,琼脂加入600mL蒸馏水中。然后分别搅拌均匀,煮沸溶解。冷至80℃左右时,先将硫酸亚铁和磷酸氢二钠混匀,倒入基础液中,混匀。
将柠檬酸铋铵和亚硫酸钠混匀,倒入基础液中,再混匀。调节pH至7.5±0.2,随即倾入琼脂液中,混合均匀,冷至50℃~55℃。加入煌绿溶液,充分混匀后立即倾注平皿。
标准中,之所以将不同的成分分组溶解,按照一定的条件和顺序混合,就是为了避免或减少这些成分之间相互反应,形成不溶物。实际使用过程中,为了使用的方便,通常将培养基成分进行混合,形成干粉混合物,再根据需要制成平板使用。这就不可避免地会使倾注的平板上自带黑渣。那么这些黑渣的存在对实验效果有没有影响?又怎样能将这种影响尽量降低呢?下面我们来看一组实验:
首先,在室温条件下,按比例配制200mlBS培养基,充分搅拌,使里面的成分溶解完全,然后按照常规方法加热煮沸灭菌,加热过程中不断搅拌,避免粘底糊化,冷却至50℃-55℃,不再做任何搅拌,直接依次倾入10个平皿并编号。倾倒时会发现,开始的几个平板黑渣较少,越往底部,黑渣越多,最后再搪瓷缸底部会沉淀下大量的黑色不溶物。如图二:

图二
倾倒出的平板上有明显黑渣,如图三:
图三
将沙门氏菌在制好的平板上进行划线、培养,会发现,开始倾倒的几个平板上,3区都能长出,且菌落直径较大,而最后倾注的平板上,沙门氏菌的生长明显受到影响,且菌落直径偏小。如图四:
图四
作为对比试验,倾倒的过程中,不断搅拌,倾注成的平板就会比较均匀,搪瓷缸底物几乎没有黑渣沉淀下来,其实这个道理很简单,就是在搅拌的过程中,将原本形成的黑色不溶物均匀地分散到所有平皿中去了。倒出的平皿如图五:
图五
沙门氏菌在这一组平板上的生长特征基本一致,没有明显差别。如图六:
图六
通过上面的试验,我们可以看到,只要在倾倒平板的过程中持续进行搅拌,倾倒完毕,搪瓷缸底部就不会有很多黑渣,并且倒出的平板没有黑渣聚集的现象。沙门氏菌的生长也比较均一。对菌落的影响不明显。不影响培养基的使用。
在使用过程中,只要把握“均匀搅拌”这一原则,就可以很好地使用这款培养基,而不能一味纠结于平板上的黑渣。因为这是不可避免的。
五、注意事项
GB4789.4中特别指出,本培养基不需要高压灭菌,在制备过程中不宜过分加热,避免降低其选择性,贮于室温暗处,超过48h会降低其选择性,本培养基宜于当天制备,第二天使用。
对此,分别用放置24h和当天配制的BS平板进行划线试验对比,结果如图七:

图七
从图中可以看出,放置24h后使用,划线菌落明显比当天配制当天使用长得好一些,现配现用,由于抑制性太强,容易导致有些目标菌生长不出来,造成漏检。
有关目标菌的生长对比,还可以参考:亚硫酸铋琼脂配置后不同使用时间目标菌的生长对比。
六、参考文献
[1] GB 4789.4-2016 食品安全国家标准 食品微生物学检验 沙门氏菌检验。
[2] 高广尧,开丽红 禽沙门氏菌的危害及控制。
[3] 董兴安,雄伟,遇丽 N 掺杂Bi2O2CO3/氧化石墨烯分级结构的合成及其可见光催化性能研究。
注:本文属海博生物原创,未经允许不得转载。
上一篇:培养基出现沉淀的原因
下一篇:浅谈无菌室洁净度检测与灭菌方式



